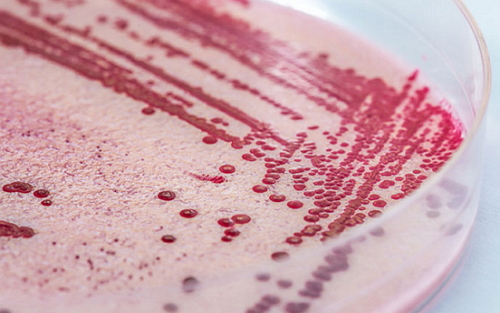

细菌摧毁入侵病毒的能力一直令科学家们迷惑不解。日前,约翰霍普金斯大学(Johns Hopkins University)的研究人员对细菌免疫系统进行了深入研究,揭开了它们快速识别入侵者的秘诀。
细菌一直在与病毒或入侵核酸进行斗争,为此它们演化出了多种防御机制,CRISPR适应性免疫系统就是其中之一。CRISPR系统由小RNA分子引导,可以靶标和沉默入侵者的遗传信息。
发现CRISPR系统后不久,人们就开始用它来编辑DNA和修复受损的基因。这种基因组编辑技术更易于操作,也具有更强的扩展性,很快便引起了人们极大的研究热情。之前曾有研究者曾利用CRISPR系统,从感染了HIV的人类细胞中切除病毒DNA。
监控复合物Cascade(CRISPR-associated complex for antiviral defense)是CRISPR系统中的一个关键组分,也是细菌细胞的重要守卫。Cascade通过RNA扫描噬菌体DNA,确定它是否来自于入侵者。一旦认定外源DNA,细胞就会发动攻击将其粉碎。Cascade由11种蛋白组成的,只有所有部分都正常运转,才能发挥自己的正常功能。
研究人员在Cascade与其靶标(ssDNA)结合时进行结晶,并通过高能X射线解析了复合体的精密结构。他们发现Cascade具有一个非常独特的绳梯结构,这一发现刊登在了近期出版的Science杂志上。
这项研究的领导者,副教授Scott Bailey说:“结构可以帮助我们了解分子机器的作用机制这项研究为人们展示了一个前所未见的独特结构,而这种结构就是Cascade成功的秘诀。”
研究人员发现,Cascade中的RNA和DNA并没有彼此缠绕形成双螺旋,而是相互平行组成了一个绳梯。Bailey指出,如果Cascade RNA与DNA相互缠绕,那么在检查下一个DNA时就需要打开缠绕,无形中延长了抵御感染的时间。而梯子结构允许RNA快速扫描DNA。
研究显示,RNA扫描DNA的方式,就像人们利用关键词进行快速浏览。它们将长序列分成小段(就像段落与词句),以便快速发现问题。
这项研究为人们进一步解析了Cascade的作用机制,这样的信息可以帮助人们更好地使用CRISPR工具进行DNA编辑甚至治疗疾病。此外,这项研究也为理解细菌耐药性的产生提供了线索。许多致病菌都能对抗生素药物产生抗性,WHO已经将这一问题视为全球公共健康面临的主要威胁。







